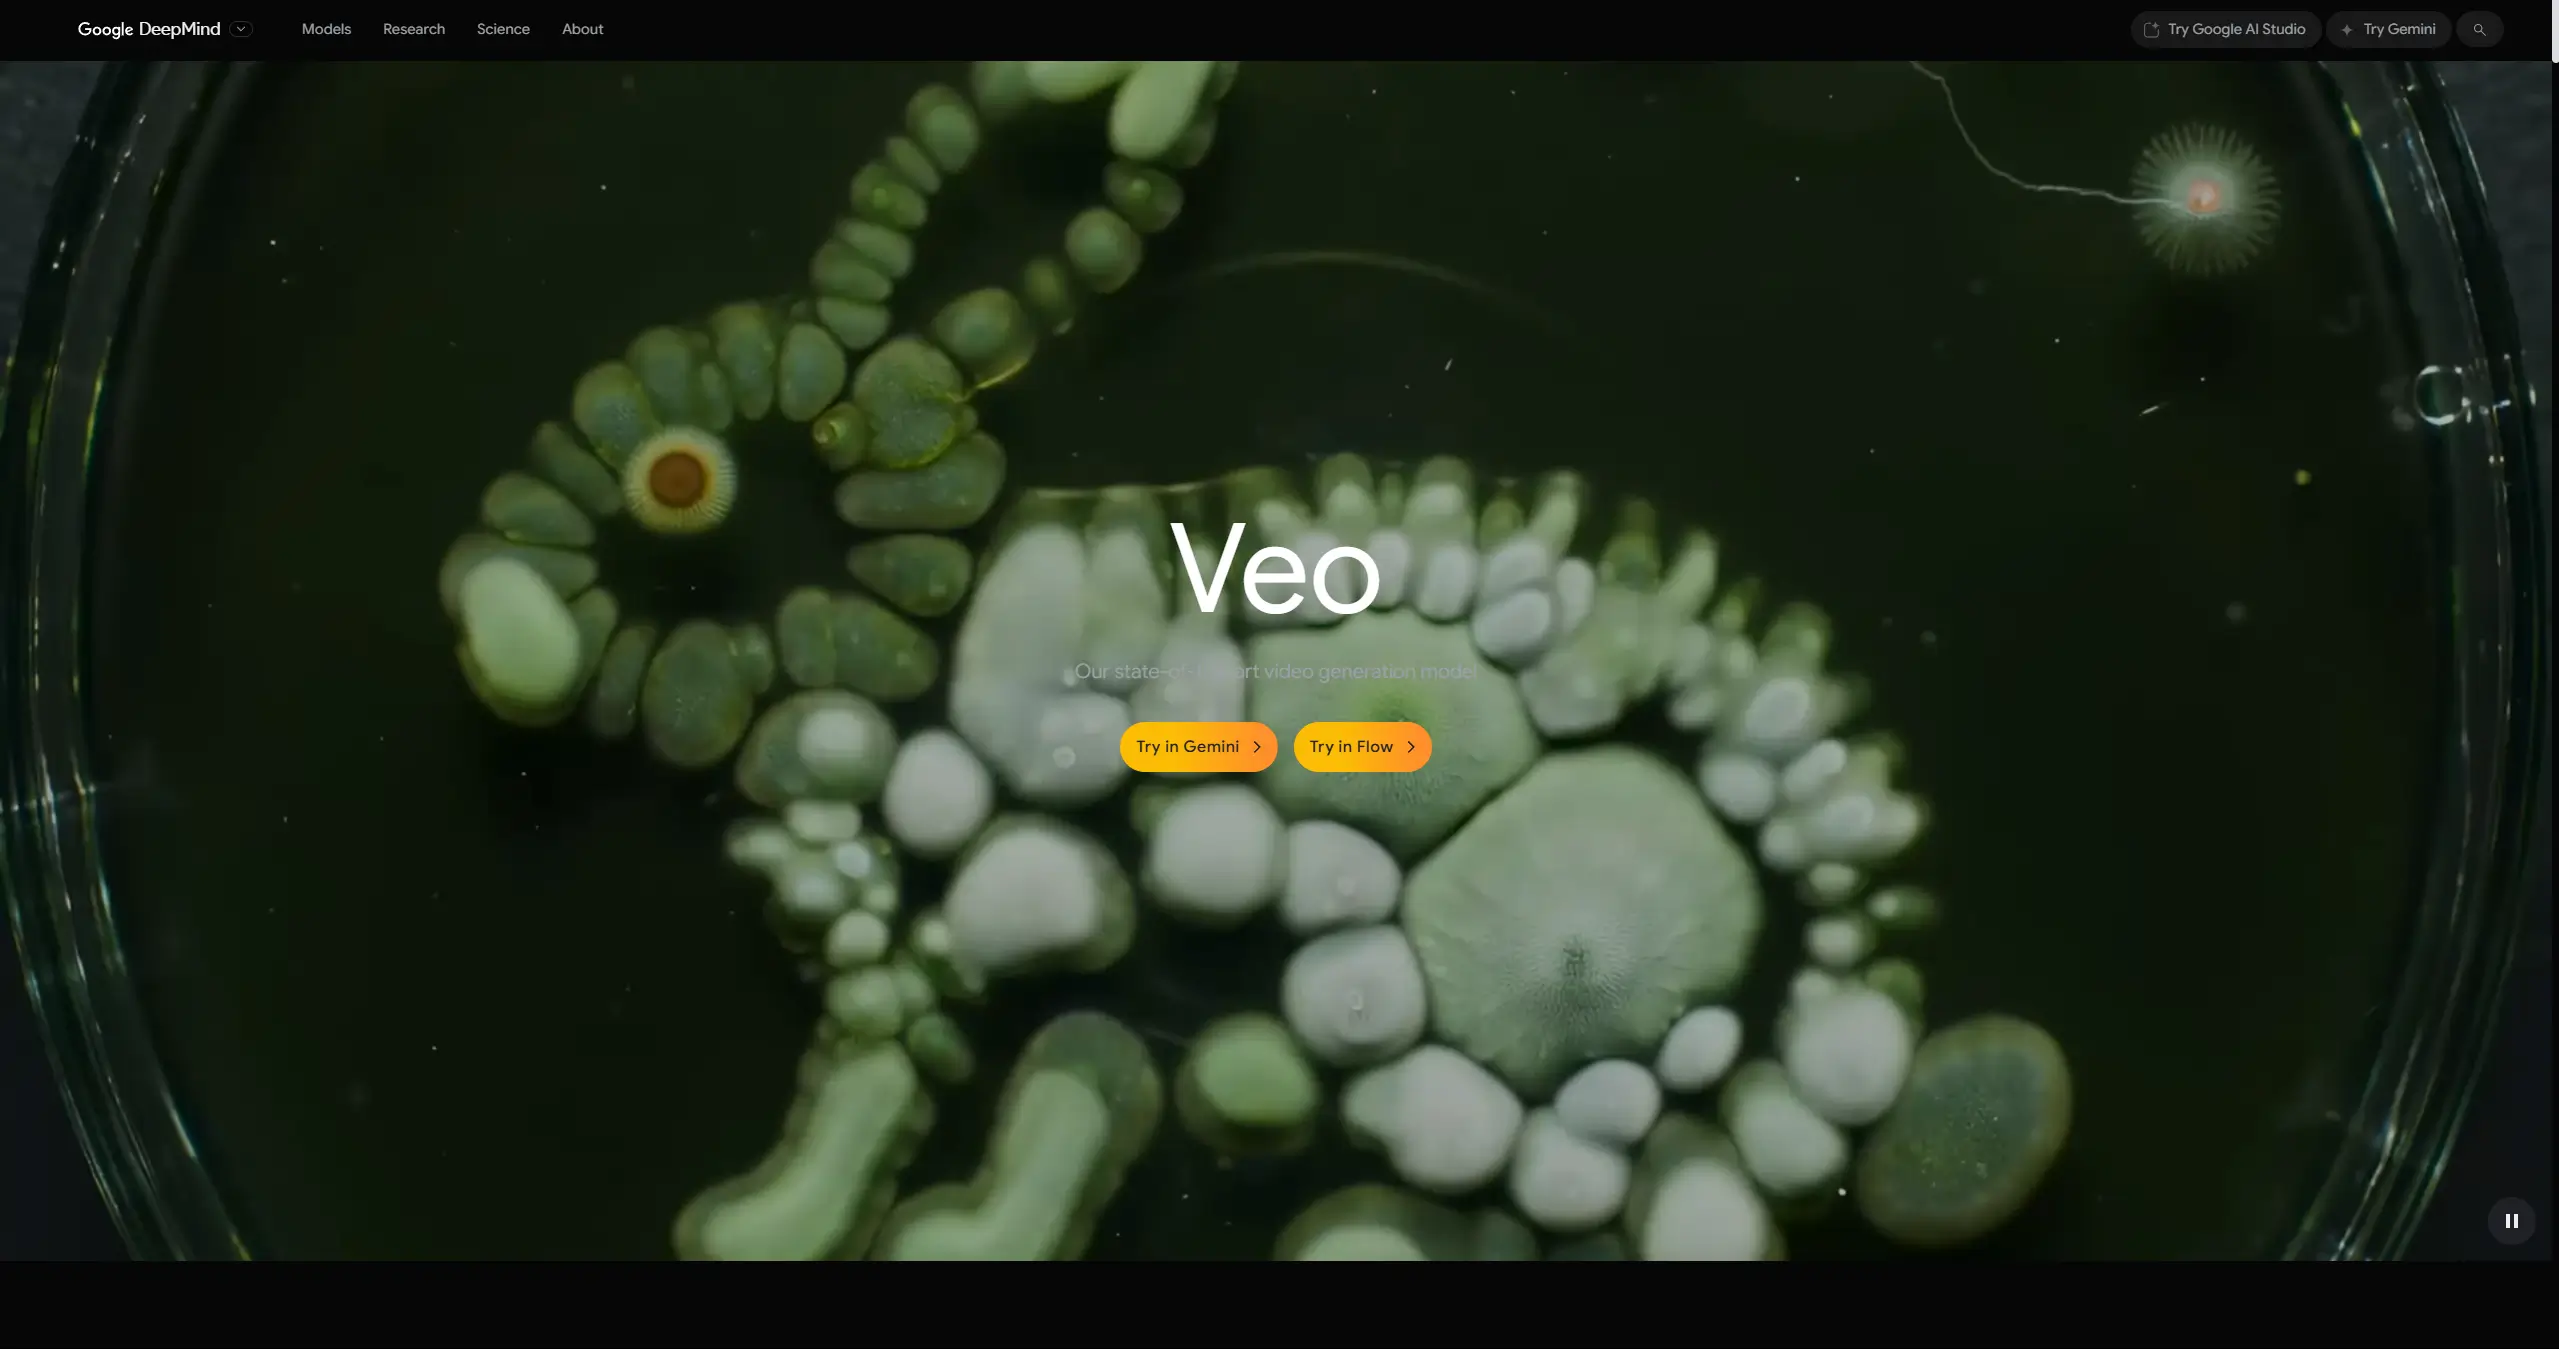
SITE DA VEO3

Recentemente no dia 20 de maio de 2025, em uma conferência, o google lançou a sua nova IA, o VEO3, esta inteligencia artificial causou um verdadeiro movimento nas redes sociais, diversos vídeos tem sido lançados na internet feito totalmente através dessa ferramenta.
Ela apresenta uma narração de alta qualidade em qualquer idioma, imagens extremamente realistas, vamos ver como as utilizar nas suas redes sociais para ter um maior engajamento com seus clientes.
O Que é o VEO3?
O VEO3 é um sistema de inteligência artificial desenvolvido pelo Google, pensado para transformar a relação das pessoas com vídeos na internet. Essa plataforma usa algoritmos avançados para buscar, analisar e criar conteúdos audiovisuais de maneira automática. O que torna o VEO3 diferente de outros programas é a sua capacidade de entender melhor o contexto do vídeo, reconhecendo cenas, falas, e até sentimentos transmitidos nas imagens, o que facilita a organização e o destaque de conteúdos relevantes.
Quando falamos em usar IA para redes sociais, o VEO3 entra como uma ferramenta que pode gerar vídeos prontos para publicação, otimizados para engajamento e alcance maior. Com suas tecnologias, é possível criar materiais em poucos minutos, pensando desde roteiros até sugestões de edição alinhadas ao que mais chama atenção do público. O algoritmo do VEO3 analisa tendências, palavras mais buscadas e até o comportamento dos seguidores, sugerindo conteúdos que realmente fazem diferença nas redes sociais.
Além de ajudar a produzir de maneira rápida, o VEO3 também permite que pessoas sem experiência em edição desenvolvam conteúdos visuais de qualidade, focando em entregar o que está em alta e gerando engajamento sem precisar dominar ferramentas complicadas. Em resumo, ele é uma solução que conecta inteligência artificial com produção de vídeos, mostrando como é possível transformar estratégias digitais e automatizar publicações de forma prática e eficiente.
Como Criar Vídeo com o VEO3?

Acesse o site oficial da VEO3 https://deepmind.google/models/veo/, aqui você terá duas opções de criar vídeo com IA, a primeira é a “try in gemini” e a segunda é a “try in flow”, vale a pena explorar as duas, mas aqui vamos nos ater apenas a “try in flow”. Nele você acessará o painel do gemini e poderá criar vídeo através dele, segue nosso tutorial a seguir.
Criando vídeo através do prompt

Após você acessar o gemini, você deve utilizar um prompt para criar o vídeo, recomendamos que você faça uma pesquisa aprofundada sobre as ideias de prompt e peça ajuda ao chatgpt. Lembrando que você tem de 5-10 vídeos gerados, cada vídeo tem 8 segundos de duração.
Vale lembrar que caso você queira um vídeo em português ou com algum tipo de música, deve descrever detalhadamente no prompt. Veja esse exemplo de um prompt que utilizei:
“Em 538 a.C., Daniel está na cova dos leões, gravando um vídeo tipo selfie enquanto anda. Ele tem a aparência de alguém que pratica trabalho duro, com roupas simples e robustas da época. Os leões ao fundo têm uma aparência faminta, mas mantêm distância. Daniel, exibindo seu rosto e parte do cenário ao redor até a barriga, sorri e diz: “Oi pessoal! Aqui é o Daniel, direto da cova dos leões. Estou passando para dizer que estou bem. Acreditem ou não, dormi a noite toda aqui e foi tranquilo! Os leões são mais gentis do que parecem. Obrigado a todos pela preocupação, continuem com fé e tudo vai dar certo!” A iluminação da cova é suave, destacando a serenidade da cena. O audio precisa vir em portugues”
Dowload do vídeo

Esse será o resultado final do vídeo, faça o dowload dele no canto superior direito e pronto. Com esses trechos de 8 segundos você pode montar diversas histórioas de alta qualidade.
Exemplo do vídeo criado.
Como Aplicar a Ideia nas Redes Sociais?
Você pode utilizar imagens dos clientes como base para o vídeo, assim pode usar a criatividade para montar os vídeo mais criativos para as redes sociais. Também você criar prompts criativos para anunciar seu produto, fazendo uma descrição bem feita e detalhada.
Conclusão
Sem dúvida essa é uma das ferramentas mais poderosas da atualidade, concerteza vai ajudar muito as empresas de social media e pode ser super util também para você que deseja se aprofundar mais área.